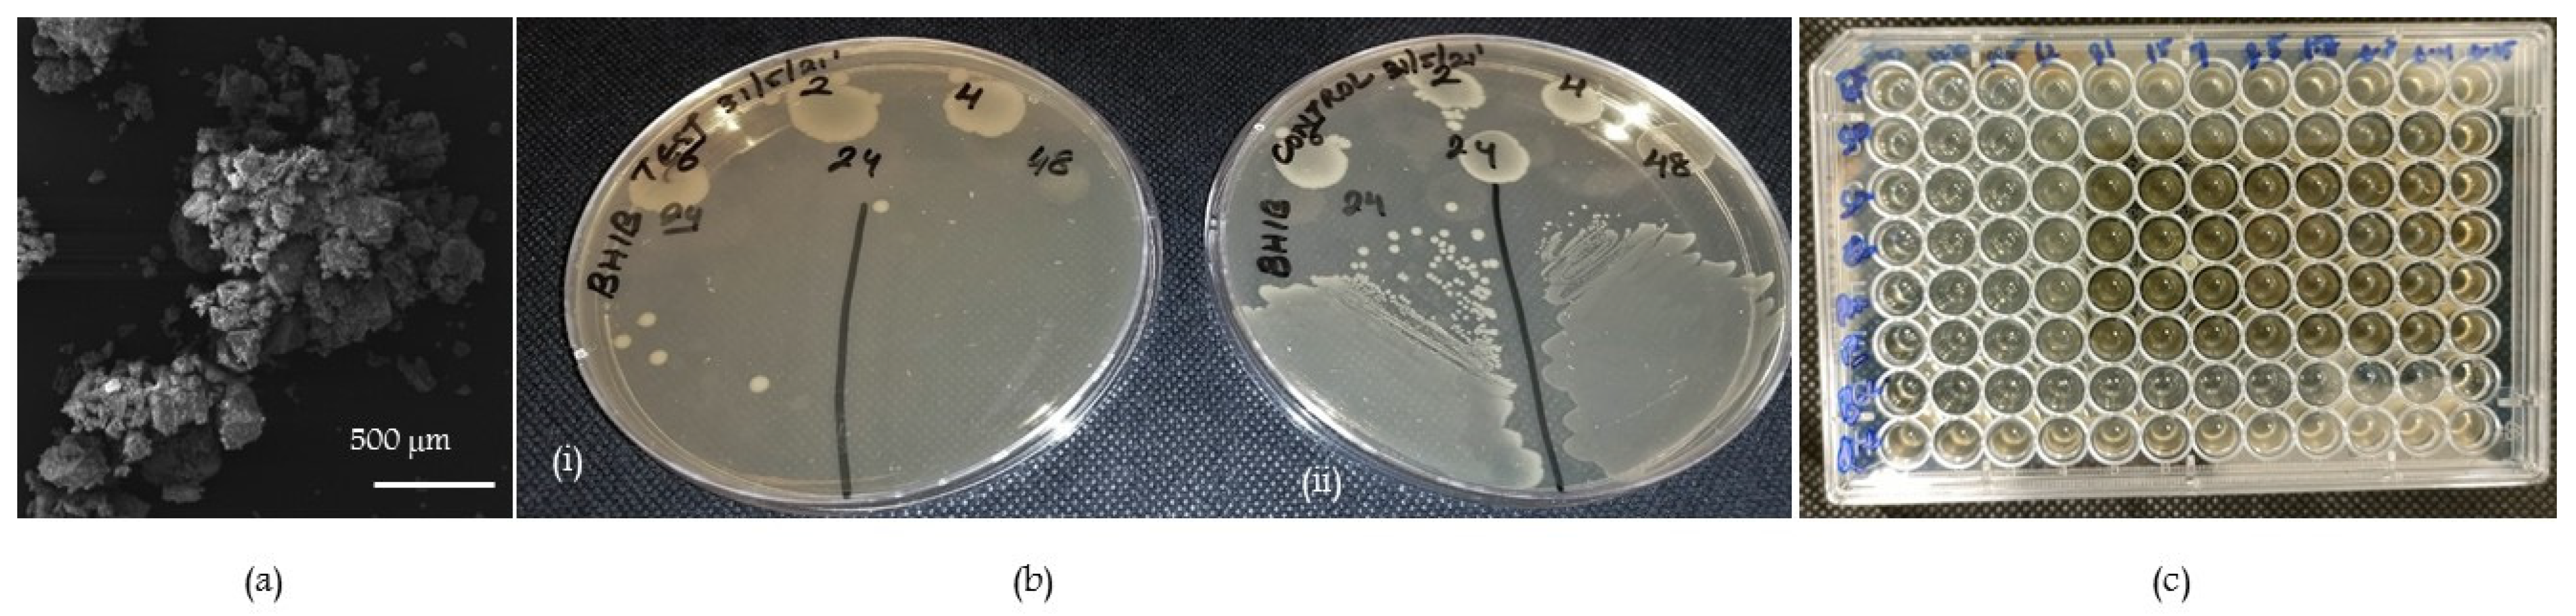
Molecules 28 03179 g001 Molecules 28 03179 g001

Antibacterial and Antibiofilm Efficacy of Copper-Doped Phosphate Glass on Pathogenic Bacteria
Abstract
1. Introduction
2. Results
2.1. Scanning Electron Microscopy
2.2. Antibacterial Activity
2.2.1. Preliminary Antibacterial Activity and Microbroth Dilution Method
2.2.2. Time-Kill Assay
2.3. Antibiofilm Activity
Confocal Laser Scanning Microscopy (CLSM) and Disruption of Biofilm
3. Discussion
4. Materials and Methods
4.1. Glass Preparation
4.2. Scanning Electron Microscopy
4.3. Antibacterial Activity
4.3.1. Preliminary Test for Antibacterial Activity
4.3.2. Detection of Minimum Inhibitory Concentration (MIC) of CDPG by the Microbroth Dilution Method
4.3.3. Time-Kill Assay
4.4. Antibiofilm Activity Using Crystal Violet Assay
Visualization of Biofilm Disruption by Confocal Laser Scanning Microscopy
4.5. Statistical Analysis
5. Conclusions
Author Contributions
Funding
Institutional Review Board Statement
Informed Consent Statement
Data Availability Statement
Acknowledgments
Conflicts of Interest
Sample Availability
References
- Kasraei, S.; Sami, L.; Hendi, S.; Alikhani, M.-Y.; Rezaei-Soufi, L.; Khamverdi, Z. Antibacterial properties of composite resins incorporating silver and zinc oxide nanoparticles on Streptococcus mutans and Lactobacillus. Restor. Dent. Endod. 2014, 39, 109–114. [Google Scholar] [CrossRef]
- Alghamdi, S. Isolation and identification of the oral bacteria and their characterization for bacteriocin production in the oral cavity. Saudi J. Biol. Sci. 2022, 29, 318–323. [Google Scholar] [CrossRef] [PubMed]
- Tominari, T.; Sanada, A.; Ichimaru, R.; Matsumoto, C.; Hirata, M.; Itoh, Y.; Numabe, Y.; Miyaura, C.; Inada, M. Gram-positive bacteria cell wall-derived lipoteichoic acid induces inflammatory alveolar bone loss through prostaglandin E production in osteoblasts. Sci. Rep. 2021, 11, 13353. [Google Scholar] [CrossRef]
- Le, M.N.-T.; Kayama, S.; Yoshikawa, M.; Hara, T.; Kashiyama, S.; Hisatsune, J.; Tsuruda, K.; Onodera, M.; Ohge, H.; Tsuga, K.; et al. Oral colonisation by antimicrobial-resistant Gram-negative bacteria among long-term care facility residents: Prevalence, risk factors, and molecular epidemiology. Antimicrob. Resist. Infect. Control 2020, 9, 45. [Google Scholar] [CrossRef] [PubMed]
- Hojo, K.; Nagaoka, S.; Ohshima, T.; Maeda, N. Bacterial interactions in dental biofilm development. J. Dent. Res. 2009, 88, 982–990. [Google Scholar] [CrossRef]
- Kolenbrander, P.E. Oral microbial communities: Biofilms, interactions, and genetic systems. Annu. Rev. Microbiol. 2000, 54, 413–437. [Google Scholar] [CrossRef]
- Aruni, A.W.; Dou, Y.; Mishra, A.; Fletcher, H.M. The Biofilm Community-Rebels with a Cause. Curr. Oral Health Rep. 2015, 2, 48–56. [Google Scholar] [CrossRef] [PubMed]
- O’Toole, G.A. Microtiter dish biofilm formation assay. J. Vis. Exp. JoVE 2011, 47, 2437. [Google Scholar] [CrossRef]
- Fernandes, G.L.; Delbem, A.C.B.; do Amaral, J.G.; Gorup, L.F.; Fernandes, R.A.; de Souza Neto, F.N.; Souza, J.A.S.; Monteiro, D.R.; Hunt, A.M.A.; Camargo, E.R.; et al. Nanosynthesis of Silver-Calcium Glycerophosphate: Promising Association against Oral Pathogens. Antibiotics 2018, 7, 52. [Google Scholar] [CrossRef] [PubMed]
- Jakubovics, N.S.; Goodman, S.D.; Mashburn-Warren, L.; Stafford, G.P.; Cieplik, F. The dental plaque biofilm matrix. Periodontology 2000 2021, 86, 32–56. [Google Scholar] [CrossRef] [PubMed]
- Saafan, A.; Zaazou, M.H.; Sallam, M.K.; Mosallam, O.; El Danaf, H.A. Assessment of Photodynamic Therapy and Nanoparticles Effects on Caries Models. Open Access Maced. J. Med. Sci. 2018, 6, 1289–1295. [Google Scholar] [CrossRef] [PubMed]
- Cao, W.; Zhang, Y.; Wang, X.; Chen, Y.; Li, Q.; Xing, X.; Xiao, Y.; Peng, X.; Ye, Z. Development of a novel resin-based dental material with dual biocidal modes and sustained release of Ag(+) ions based on photocurable core-shell AgBr/cationic polymer nanocomposites. J. Mater. Sci. Mater. Med. 2017, 28, 017–5918. [Google Scholar] [CrossRef]
- Abou Neel, E.A.; Pickup, D.M.; Valappil, S.V.; Newport, R.J.; Knowles, J.C. Bioactive functional materials: A perspective on phosphate-based glasses. J. Mater. Chem. 2009, 19, 690–701. [Google Scholar] [CrossRef]
- Abou Neel, E.A.; Ahmed, I.; Pratten, J.; Nazhat, S.N.; Knowles, J.C. Characterisation of antibacterial copper releasing degradable phosphate glass fibres. Biomaterials 2005, 26, 2247–2254. [Google Scholar] [CrossRef] [PubMed]
- Abou Neel, E.A.; Hossain, K.M.Z.; Abuelenain, D.A.; Abuhaimed, T.; Ahmed, I.; Valappil, S.P.; Knowles, J.C. Antibacterial effect of titanium dioxide-doped phosphate glass microspheres filled total-etch dental adhesive on S. mutans biofilm. Int. J. Adhes. Adhes. 2021, 108, 102886. [Google Scholar] [CrossRef]
- Abou Neel, E.A.; Roohpour, N.; Padidar, B.; Mordan, N.J.; Bozec, L. Biomimetic dentin repair with a dual-analogue phosphate glass-polyacrylate paste: A proof-of-concept. Mater. Chem. Phys. 2021, 266, 124539. [Google Scholar] [CrossRef]
- Valappil, S.P.; Coombes, M.; Wright, L.; Owens, G.J.; Lynch, R.J.; Hope, C.K.; Higham, S.M. Role of gallium and silver from phosphate-based glasses on in vitro dual species oral biofilm models of Porphyromonas gingivalis and Streptococcus gordonii. Acta Biomater. 2012, 8, 1957–1965. [Google Scholar] [CrossRef]
- Abou Neel, E.A.; Kiani, A.; Valappil, S.P.; Mordan, N.M.; Baek, S.-Y.; Hossain, K.M.Z.; Felfel, R.M.; Ahmed, I.; Divakarl, K.; Chrzanowski, W.; et al. Glass microparticle- versus microsphere-filled experimental dental adhesives. J. Appl. Polym. Sci. 2019, 136, 47832. [Google Scholar] [CrossRef]
- Abou Neel, E.A.; Young, A.M.; Nazhat, S.N.; Knowles, J.C. A Facile synthesis route to prepare microtubes from phosphate glass fibres. Adv. Mater. 2007, 19, 2856–2862. [Google Scholar] [CrossRef]
- Abou Neel, E.A.; Chrzanowski, W.; Knowles, J.C. Effect of increasing titanium dioxide content on bulk and surface properties of phosphate-based glasses. Acta Biomater. 2008, 4, 523–534. [Google Scholar] [CrossRef]
- Abou Neel, E.A.; Mizoguchi, T.; Ito, M.; Bitar, M.; Salih, V.; Knowles, J.C. In vitro bioactivity and gene expression by cells cultured on titanium dioxide doped phosphate-based glasses. Biomaterials 2007, 28, 2967–2977. [Google Scholar] [CrossRef]
- Marovic, D.; Haugen, H.J.; Negovetic Mandic, V.; Par, M.; Zheng, K.; Tarle, Z.; Boccaccini, A.R. Incorporation of copper-doped mesoporous bioactive glass nanospheres in experimental dental composites: Chemical and mechanical characterization. Materials 2021, 14, 2611. [Google Scholar] [CrossRef] [PubMed]
- Angelé-Martínez, C.; Nguyen, K.V.T.; Ameer, F.S.; Anker, J.N.; Brumaghim, J.L. Reactive oxygen species generation by copper(II) oxide nanoparticles determined by DNA damage assays and EPR spectroscopy. Nanotoxicology 2017, 11, 278–288. [Google Scholar] [CrossRef] [PubMed]
- Foroutan, F.; McGuire, J.; Gupta, P.; Nikolaou, A.; Kyffin, B.A.; Kelly, N.L.; Hanna, J.V.; Gutierrez-Merino, J.; Knowles, J.C.; Baek, S.Y.; et al. Antibacterial Copper-Doped Calcium Phosphate Glasses for Bone Tissue Regeneration. ACS Biomater. Sci. Eng. 2019, 5, 6054–6062. [Google Scholar] [CrossRef] [PubMed]
- Schroeder, M.; Brooks, B.D.; Brooks, A.E. The complex relationship between virulence and antibiotic resistance. Genes 2017, 8, 39. [Google Scholar] [CrossRef]
- Yang, Y.-I.; Jung, D.-W.; Bai, D.G.; Yoo, G.S.; Choi, J.-K. Counterion-dye staining method for DNA in agarose gels using crystal violet and methyl orange. Electrophoresis 2001, 22, 855–859. [Google Scholar] [CrossRef] [PubMed]
- Bonnekoh, B.; Wevers, A.; Jugert, F.; Merk, H.; Mahrle, G. Colorimetric growth assay for epidermal cell cultures by their crystal violet binding capacity. Arch. Derm. Res. 1989, 281, 487–490. [Google Scholar] [CrossRef] [PubMed]
- Colvin, K.M.; Gordon, V.D.; Murakami, K.; Borlee, B.R.; Wozniak, D.J.; Wong, G.C.; Parsek, M.R. The pel polysaccharide can serve a structural and protective role in the biofilm matrix of Pseudomonas aeruginosa. PLoS Pathog. 2011, 7, 1001264. [Google Scholar] [CrossRef]
- Hill, C. Virulence or niche factors: What’s in a name? J. Bacteriol. 2012, 194, 5725–5727. [Google Scholar] [CrossRef]
- Chahal, G.; Quintana-Hayashi, M.P.; Gaytán, M.O.; Benktander, J.; Padra, M.; King, S.J.; Linden, S.K. Streptococcus oralis Employs Multiple Mechanisms of Salivary Mucin Binding That Differ Between Strains. Front. Cell. Infect. Microbiol. 2022, 12, 597. [Google Scholar] [CrossRef]
- Vestby, L.K.; Grønseth, T.; Simm, R.; Nesse, L.L. Bacterial biofilm and its role in the pathogenesis of disease. Antibiotics 2020, 9, 59. [Google Scholar] [CrossRef]
- Weinstein, M.P.; Lewis, J.S. 2nd. The Clinical and Laboratory Standards Institute Subcommittee on Antimicrobial Susceptibility Testing: Background, Organization, Functions, and Processes. J. Clin. Microbiol. 2020, 58, e01864-19. [Google Scholar] [CrossRef] [PubMed]
- Richard Schwalbe, L.S.-M.; Avery, C.G. Methods for Determining Bactericidal Activity and Antimicrobial Interactions: Synergy Testing, Time-Kill Curves, and Population Analysis; CRC Press: Boca Raton, FL, USA, 2007. [Google Scholar]
- Adusei, E.B.A.; Adosraku, R.K.; Oppong-Kyekyeku, J.; Amengor, C.D.K.; Jibira, Y. Resistance Modulation Action, Time-Kill Kinetics Assay, and Inhibition of Biofilm Formation Effects of Plumbagin from Plumbago zeylanica Linn. J. Trop. Med. 2019, 26, 125064. [Google Scholar] [CrossRef] [PubMed]
- Coffey, B.M.; Anderson, G.G. Biofilm formation in the 96-well microtiter plate. Methods Mol. Biol. 2014, 1149, 631–641. [Google Scholar] [PubMed]
- Goodman, S.D.; Bakaletz, L.O. Bacterial Biofilms Utilize an Underlying Extracellular DNA Matrix Structure That Can Be Targeted for Biofilm Resolution. Microorganisms 2022, 10, 466. [Google Scholar] [CrossRef]

Disclaimer/Publisher’s Note: The statements, opinions and data contained in all publications are solely those of the individual author(s) and contributor(s) and not of MDPI and/or the editor(s). MDPI and/or the editor(s) disclaim responsibility for any injury to people or property resulting from any ideas, methods, instructions or products referred to in the content. |
© 2023 by the authors. Licensee MDPI, Basel, Switzerland. This article is an open access article distributed under the terms and conditions of the Creative Commons Attribution (CC BY) license (https://creativecommons.org/licenses/by/4.0/).
Share and Cite
Shetty, S.; Sekar, P.; Shetty, R.M.; Abou Neel, E.A. Antibacterial and Antibiofilm Efficacy of Copper-Doped Phosphate Glass on Pathogenic Bacteria. Molecules 2023, 28, 3179. https://doi.org/10.3390/molecules28073179
Shetty S, Sekar P, Shetty RM, Abou Neel EA. Antibacterial and Antibiofilm Efficacy of Copper-Doped Phosphate Glass on Pathogenic Bacteria. Molecules. 2023; 28(7):3179. https://doi.org/10.3390/molecules28073179
Chicago/Turabian StyleShetty, Sunaina, Priyadharshini Sekar, Raghavendra M. Shetty, and Ensanya Ali Abou Neel. 2023. "Antibacterial and Antibiofilm Efficacy of Copper-Doped Phosphate Glass on Pathogenic Bacteria" Molecules 28, no. 7: 3179. https://doi.org/10.3390/molecules28073179
APA StyleShetty, S., Sekar, P., Shetty, R. M., & Abou Neel, E. A. (2023). Antibacterial and Antibiofilm Efficacy of Copper-Doped Phosphate Glass on Pathogenic Bacteria. Molecules, 28(7), 3179. https://doi.org/10.3390/molecules28073179

